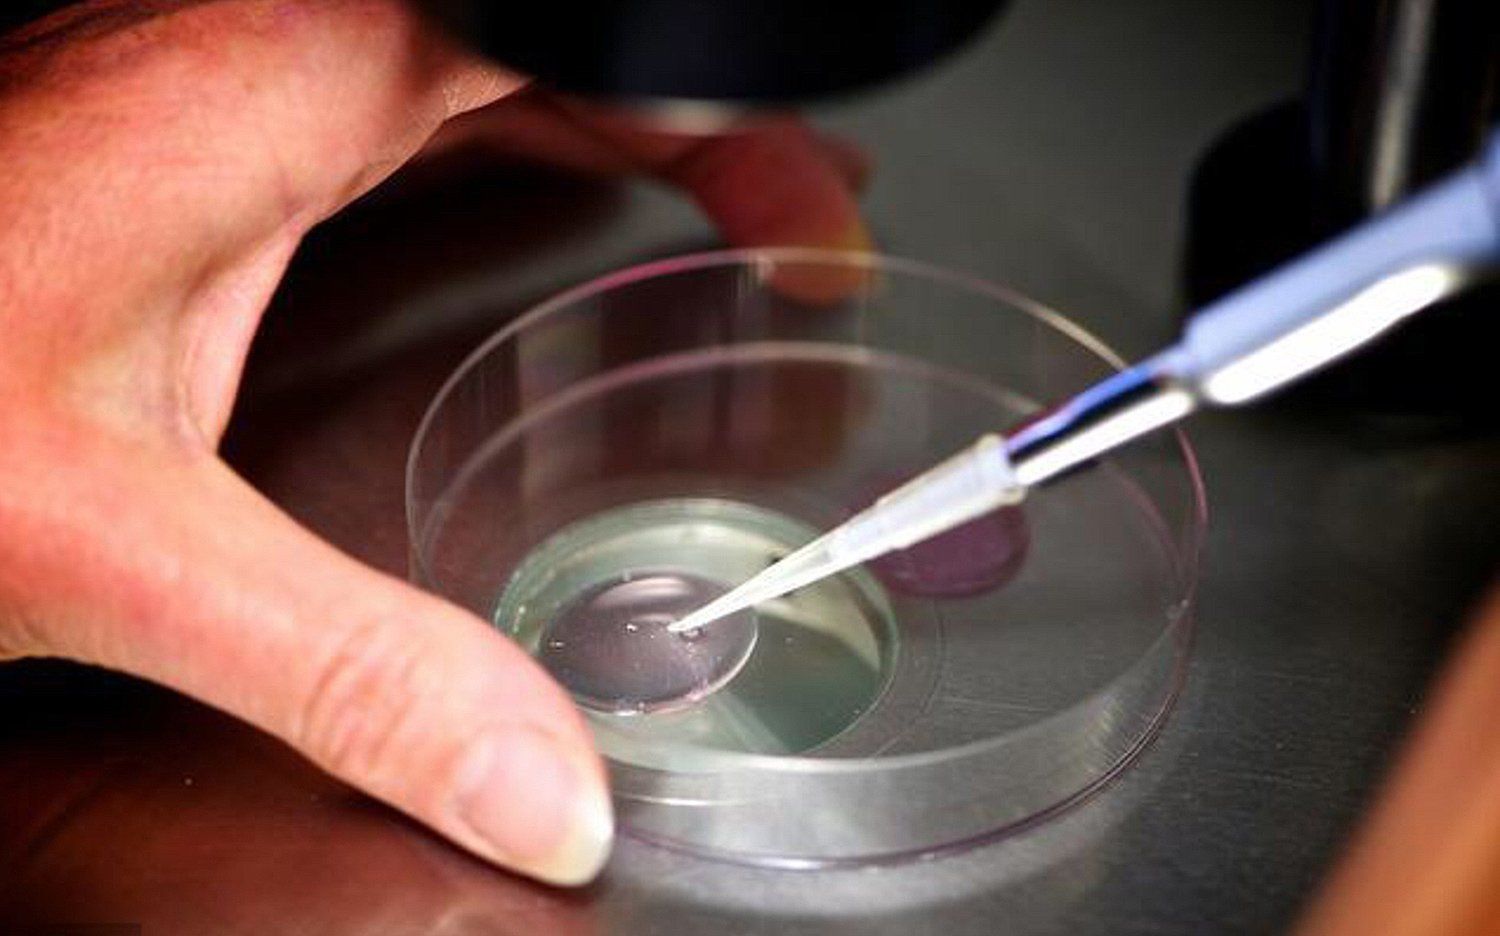
Infertility Care

Top IVF USA Photo Gallery
Free Consultations | Free Analyses | Over 40 Years of Experience
Free Consultations
Free Analyses
Over 40 Years of Experience
Build Your Family With the Help of Top IVF USA
The photos below show Dr. Wang doing what he does best — helping families just like yours overcome fertility problems to create the children they want! If you've struggled to build your family, please call or email us today.

Share On: